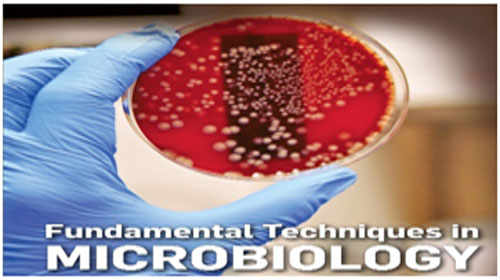

What Students Say
Feedback
QA Officer
Course is very nice and modules are quite knowledgeable and very helpful. Courses are interesting and relevant”

Jyoti Maurya
Trends Pharma, Gujrat (India)
QA Chemist
The course is precise and contents is very informative” “Very clear and updated – it has broadened my understanding of Pharmaceutical knowledge”

Shivam Rai
IPCA laboratories, Sikkim (India)
Executive QA
“The module as a whole is very well delivered and the lecturer makes it interesting and therefore making a good learning experience”

Neeraj Rawat
Sanofi , Goa (India)
Sr. Officer QA
Course is very nice and lecturer is also quite interesting and very helpful. “Detailed explanations and clarity”

Prabhat Sharma
Naari Pharma, Rudrapur (India)
Executive
The content of the module is interesting. The content is relevant and useful – it is well presented in an intelligent and interesting manner”

Kuldeep Singh
Sanofi, Goa (India)
Trainee Packing
“The module as a whole is very well delivered and the contents makes it very interesting and therefore making a good learning experience”

Irfan Ahmed
Cipla, Goa (India)